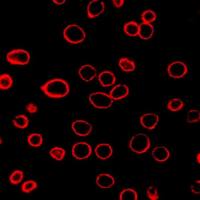
DiD（细胞膜红色荧光探针）

相关产品推荐更多 >
万千商家帮你免费找货
0 人在求购买到急需产品
- 详细信息
- 技术资料
- 供应商:
武汉恩玑生命科技有限公司
- 保存条件:
-20℃,避光保存
- 规格:
50T/300T
| 规格: | 50T | 产品价格: | ¥660.0 |
|---|---|---|---|
| 规格: | 300T | 产品价格: | ¥2320.0 |
基本信息
|
中文名称 |
Fluorescein 633-Phalloidin(荧光素633标记鬼笔环肽) |
|
英文名称 |
Fluorescein 633-Phalloidin |
|
产品规格 |
50T、300T |
|
存储条件 |
-20℃,避光保存 |
|
运输条件 |
低温 |
|
有效期 |
12个月 |
Fluorescein 633激发/发射波长:630/650nm
产品介绍
鬼笔环肽(Phalloidin)是一种来源于毒蕈类鬼笔鹅膏(Amanita phalloides)的环状七肽毒素,以高亲和力(Kd= 20 nM) 选择性结合于丝状肌动蛋白 F-actin,而不会与单体肌动蛋白 G-actin 结合,通常用来标记组织切片,细胞培养物或无细胞体 系中的 F-actin,从而对 F-actin 进行定性和定量分析。另外,鬼笔环肽衍生物也以相近的亲和力结合于大小纤维,无论是动植物来源的肌肉细胞或非肌肉细胞,按照每一个肌动蛋白亚基约与一个鬼笔环肽分子的计量比结合。且非特异性结合几乎可忽略,染色区域和非染色区域辨识度非常明显。因此,鬼笔环肽衍生物特别适合替代肌动蛋白(Actin)抗体进行相关研究。 另外鬼笔环肽衍生物很小,直径约 12-15Å,分子量<2000 Daltons,未标记肌动蛋白(Actin)的许多生理特性都得以维持, 比如,同肌动蛋白结合蛋白如肌球蛋白,原肌球蛋白,DNase I 等仍能发生反应;鬼笔环肽标记的纤维丝仍可穿透固相肌球 蛋白基质;以及甘油抽提的肌纤维标记后仍可收缩等。
试剂制备
Fluorescein 633标记的鬼笔环肽:取适量无菌水溶解管中冻干的粉末,制备成 200T/mL 的储液(300T 规格染料加入 1.5 mL 的液体,50T 规格染料加入 0.25 mL 的液体即可)。
Fluorescein 633标记鬼笔环肽的一个单位(T)的定义是染色一个加载细胞的载玻片所用染料的量。对于Fluorescein 633标记的鬼笔环肽,使用时的推荐稀释比例为 1: 40-1: 200,一个单位相当于 200 μL 总染色体积中加入 1-5 μL 200T/mL 储备溶液。
注:稀释比例可以根据实际染色效果进行适当调整。
注意事项
1. 荧光染料均存在淬灭问题,请尽量注意避光,以减缓荧光淬灭。
2. 为避免反复冻融,可对本产品进行小量分装。
风险提示:丁香通仅作为第三方平台,为商家信息发布提供平台空间。用户咨询产品时请注意保护个人信息及财产安全,合理判断,谨慎选购商品,商家和用户对交易行为负责。对于医疗器械类产品,请先查证核实企业经营资质和医疗器械产品注册证情况。
技术资料暂无技术资料 索取技术资料